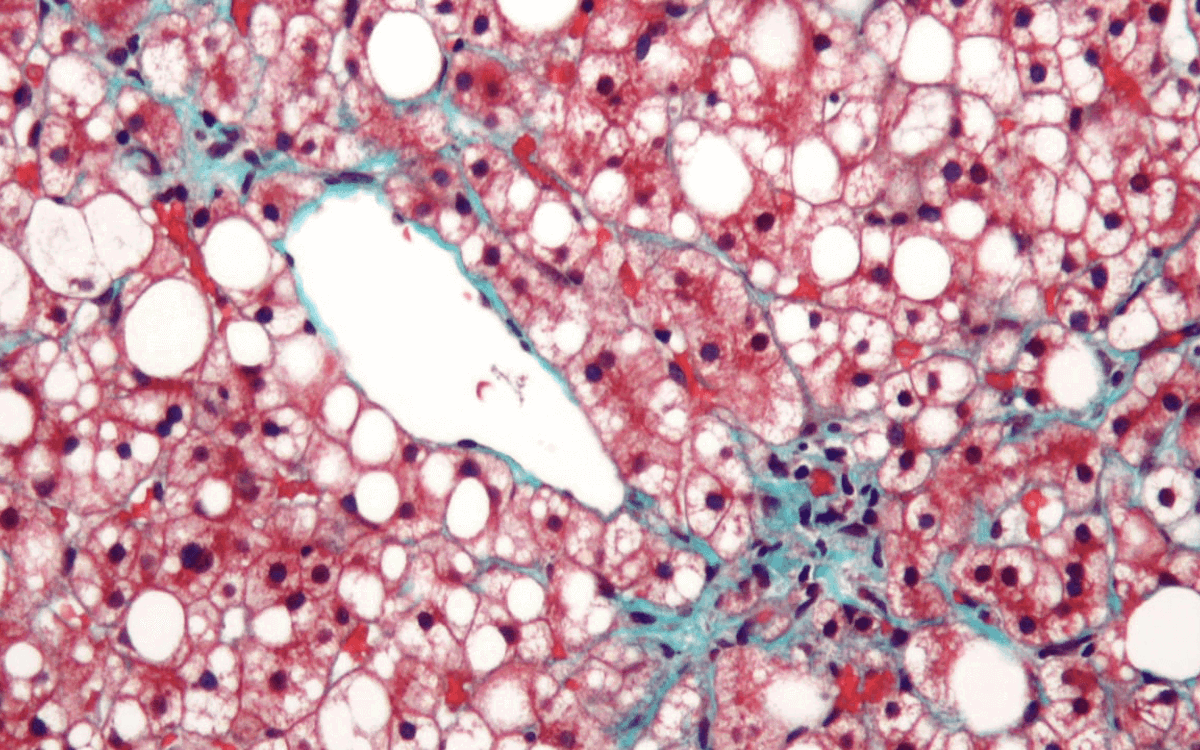

Stay informed of the latest research and clinical developments relating to this Focus Area. Here you will find updates on the work of our clinical and basic leads, and expert panel, details of upcoming training and events, and links to recent news and publications.

The ESE Focus Area on Diabetes, Obesity, Metabolism and Nutrition comprises a wide field of endocrinology with tremendous socioeconomic impact due to the rapid increase of the prevalence of these diseases.
The fascinating developments within this field have attracted our interest for many years and occupy a large portion of our time spent in both basic research and patient care. The many significant new insights into the pathogenesis of the various disorders and the availability of new treatment modalities, often based on findings from basic research, have revolutionised this area in the recent decades. The ultimate hope is not only being able to treat these diseases, but to develop ways to prevent their manifestation.
Through the Focus Area on Diabetes, Obesity, Metabolism and Nutrition we hope to improve networking and collaboration between researchers and healthcare professionals, leading to a better understanding of these conditions and helping move towards this goal.
Clinical Lead: Tricia Tan, UK
Basic Lead: Ruben Nogueiras, Spain
Expert Panel: Gema Frühbeck (Spain), Jens-Christian Holm (Denmark), Peter Kühnen (Germany), Volkan Yumuk (Turkey), Aleš Skvarča (Slovenia)
To browse all upcoming dates, events and training, go to Events and Key Dates
To see all published guidelines, journals, reports and statements, view all publications